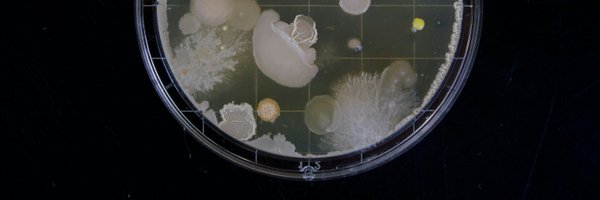
TechMechanix Profile Banner

Tech Mechanix
@TechMechanix
Followers
20
Following
5K
Media
79
Statuses
142
Future Tech 🚀 | Wild Science 🧬 | Real Breakthroughs 🔬 Daily facts, News & Explainers.
Planet Earth
Joined May 2010
The terrifying fungus that infects humans in The Last of Us is inspired by a real parasite called Cordyceps, which infects insects and alters their behaviour essentially turning ants into "zombies" before sprouting spores from their bodies. In nature, real Cordyceps species
0
0
1
Platypuses are one of the few monotreme mammals, meaning they lay eggs instead of giving live birth. After the eggs hatch, the mother produces milk, but without nipples the milk is released through specialized skin glands and pools in grooves in her fur, where the babies lap it
0
0
2
Japan's state-backed chip venture Rapidus is building a cutting-edge foundry in Hokkaido to produce 2 nanometer logic chips aiming to begin commercial production by 2027. Supported by the government and major companies including Sony, Toyota, NEC, NTT, SoftBank and IBM, Rapidus
0
0
1
Very hot water strips the scalp of its natural oils, disrupting the skin barrier that protects hair follicles. This leads to dryness, irritation, increased dandruff, and weaker hair strands that break more easily. Heat also causes the hair cuticle to lift, making hair rough,
0
0
3
French inventor Christian Poincheval created PilulePet pills designed to reduce the odor of flatulence and even make it smell like chocolate or roses. The capsules use plant-based charcoal and fennel to neutralize sulfur compounds during digestion. It sounds like a joke, but
0
0
3
🧊 Quantum Computing Took a Practical Leap Microsoft unveiled its Majorana-1 quantum chip using topological qubits, dramatically reducing errors and bringing real-world quantum computers closer than ever.
0
0
2
⚛️ A Battery That Can Last 100 Years A Chinese company revealed a carbon-14 nuclear battery prototype capable of powering devices for a century without recharging redefining long-term energy storage.
2
0
1
🧠 Personalized Gene Editing Saved a Baby’s Life For the first time, doctors used custom gene therapy to treat a newborn with a fatal genetic disorder marking a turning point for precision medicine.
1
0
0
🎨 A New Color Humans Can’t Naturally See Researchers identified a previously unknown color, “Olo,” visible only through special technology. Only five people have seen it suggesting human vision is far more limited than we assumed.
1
0
0
🧬 A Living Animal That Photosynthesizes Scientists confirmed that the sea slug Elysia chlorotica can survive by converting sunlight into energy, like a plant blurring the line between animal and leaf.
1
0
0
🎇 2025 quietly rewrote the rules of science from living solar-powered animals to quantum chips that bend https://t.co/h4LG7JBiiD are five breakthroughs that truly changed how we understand life, space, and technology. 🧵 1/5 #HappyNewYear #sciencenews
1
0
2
David Bennett did not die because the pig heart failed immediately. Doctors reported that the genetically modified heart initially functioned normally, showing no signs of hyper acute rejection - a historic first. His condition later deteriorated due to a combination of factors,
0
0
2
Today’s fitness world is shifting from train harder to recover smarter. Scientists and athletes now emphasis that rest, nutrition, sleep, and nervous-system balance are as crucial as exercise itself. Quality sleep triggers growth hormone and tissue repair, while strategic cool
0
0
2
Claims say blue-light blocking glasses can reduce headaches, improve sleep, and prevent eye strain from screens. But eye experts say the evidence is not definitive; blue light does affect circadian rhythms, but most screen discomfort comes from reduced blinking and dry eyes when
0
0
2
Bucket wheel excavator (BWE), one of the largest land machines ever built. Used mainly in open-pit mining for coal, lignite, and overburden removal, it operates continuously, scooping thousands of tons of earth per hour. Some models stretch over 200 meters in length, weigh more
0
0
2
The International Diabetes Federation has formally recognised Type 5 diabetes, A form linked to malnutrition and early-life undernutrition rather than obesity, lifestyle, pregnancy, or autoimmunity. Unlike type 1 and type 2, Type 5 stems from impaired pancreatic development due
0
0
2